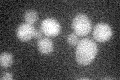
YNL275W
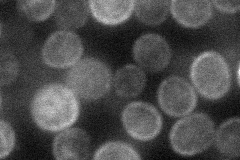
YNL275W
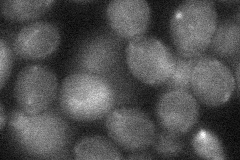
YNL275W

View description
Boron efflux transporter of the plasma membrane; binds HCO3-, I-, Br-, NO3- and Cl-; has similarity to the characterized boron efflux transporter A. thaliana BOR1
Localization:
Intensity:
Fold change:
Significance:
-
C’ GFP library in SD
below threshold15.91 -
N' NOP1pr-GFP in SD

cell periphery,ER45.4144 -
N' TEF2pr-mCherry in SD
cell periphery38.1515 -
N' NATIVEpr-GFP in SD

below threshold19.725 -
N' TEF2pr-VC and Cyto-VN in SD
below threshold28.8479 -
C’ GFP library in SD+DTT

cytosol14.510.91No -
C’ GFP library in SD+H2O2

cytosol15.480.97No -
C’ GFP library in Starvation Media

cytosol17.061.07No -
C’ GFP library on the background of Pup2-DaMP

below threshold -
C’ GFP library on the background of CCT mutant

below threshold14.10460.885613No
